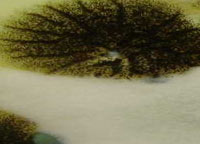
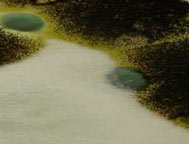

| |
The following services
are provided:
• Air sampling for fungi (mould) and bacteria
– includes both enumeration and identification
• Presence / Absence of fungi (bulk/swab)
• Identification of fungi (bulk/swab)
• Provide and Implement proper Mould abatement
procedures (i.e. personal protective equipment,
disposal, decontamination, etc.)
• Bacteria and Mould enumeration and identification
for both water and coolant (metal working
fluid) samples
• All samples are analyzed at an accredited
laboratory
|